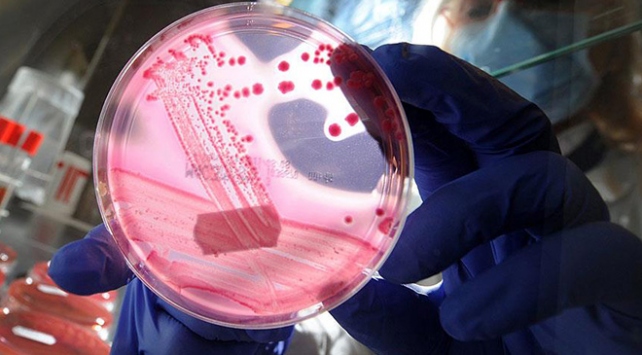
Bilim insanlarından çığır açacak keşif

Howard Hughes Tıp Enstitüsünden (HHMI) araştırmacı David Liu ve ekibi, yaptıkları araştırmada, DNA'da bulunan A*T (Adenin*Timin) bazını G*C (Guanin*Sitozin) bazına doğrudan dönüştürmeyi kolaylaştıran bir enzim keşfetti.
İnsanlarda görülen hastalıklarla ilişkili 32 bin mutasyonun neredeyse yarısına yol açan G*C bazının A*T bazına dönüşümünü tersine çevirmek isteyen bilim adamları, daha önceki deneylerinde C*G bazını, T*A bazına dönüştürmeyi başarmıştı.
Adenini hücrelerin "guanin" gibi algıladığı inosin molekülüne çeviren TadA enzimi ve bunun mutasyonlarını inceleyen bilim adamları, yaptıkları deneylerde bakterilerde oluşan mutasyonların bir kısmını ortadan kaldırmayı başardı.
Biyolog Liu ve ekibi, daha sonra TadA enzimini, gen makası olarak adlandırılan ve genleri DNA üzerinde keserek kırpmaya ve kopyalamaya izin veren CRISPR (düzenli aralıklarla bölünmüş palindromik tekrar kümeleri) Cas9 enzimine bağladı.
Bilim adamları, deneyler sırasında ABE7.10 enzimini kullanarak hem insan hem de bakteri genlerinde yüzde 50'nin üzerinde verimlilik ve çok az istenmeyen mutasyonla A*T baz çiftini G*C çiftine dönüştürmeyi başardı.
Liu, araştırmanın sonuçlarının insanların tedavisinde kullanılması için henüz erken olduğunu belirtti.
Gen mühendisliği alanında çığır açması beklenen keşfin, gelecekte insanlarda hastalıklara neden olan mutasyonları düzeltecek DNA operasyonlarında kullanılması öngörülüyor.
Kaynak: AA